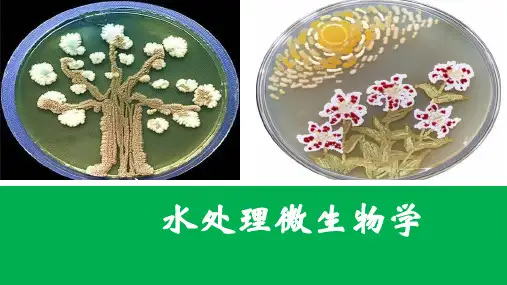

微生物生态学复习资料
- 格式:doc
- 大小:2.32 MB
- 文档页数:29

微生物生态学微生物生态学是研究微生物在多样性、功能和相互作用方面的科学学科。
它关注微生物在各种环境中的分布、丰度、活动和相互关系,涉及到土壤、水体、大气、生物体和工业等多个领域。
微生物在生态系统中扮演着重要的角色,对环境的物质循环、能量转化和生态平衡具有重要影响。
一、微生物多样性微生物是地球上最丰富的生物群体,其多样性非常丰富。
微生物的多样性涉及不同种类的细菌、真菌、病毒和原生动物等。
它们根据不同的生理特征、生活方式和环境适应能力,在不同的生态系统中扮演着不同的角色。
通过对微生物多样性的研究,我们可以了解到各种微生物的分类和分布规律,进而揭示微生物在生态系统中的功能和相互作用。
二、微生物在物质循环中的作用微生物在环境中参与了物质循环的各个环节。
例如,一些微生物能够将有机物质分解为无机物质,促进有机物质的降解和循环利用。
这些微生物被称为分解者,对于生态系统中有机物质的降解和循环具有重要意义。
另外,一些微生物也能够参与到氮、磷、硫等元素的循环过程中,促进这些元素的转化和利用。
这些微生物在生态系统的物质循环中起到了关键的作用。
三、微生物在能量转化中的作用微生物在能量转化中也起到了重要的作用。
光合微生物如藻类和光合细菌能够进行光合作用,将光能转化为化学能,并释放出氧气。
这些微生物是生态系统中的初级生产者,为其他生物提供能量来源。
而一些微生物则能够利用化学反应或者化学能转换为生物能,比如嗜热微生物可以利用地热能为能量来源,这些微生物在一些特殊环境中发挥着重要的生态功能。
四、微生物的相互作用微生物之间存在着复杂的相互作用关系。
例如,共生是微生物相互作用的一种形式。
共生关系指的是两个或多个不同种类的微生物相互依赖生存的关系。
比如植物根际微生物与植物根系之间的关系,植物通过根分泌物为微生物提供生长条件,而微生物则提供植物营养元素的转化和保护植物根系免受病原微生物侵染。
此外,微生物之间还存在竞争、共存、共同利用资源等相互作用关系,这些相互作用在微生物群落的稳定和功能上起到了重要作用。

Microbial Ecology绪论1. 名词解释:微生物生态学:是研究微生物与其周围生物和非生物环境之间相互关系的一门科学。
微生态学:是生态学的一个层次,是研究正常微生物在细胞或分子水平上相关关系的科学环境、自然环境+生物环境生境、指生物的个体、种群或群落生活地域的具体环境。
生物+非生物栖息地、生物生活或居住的范围的物理环境。
如林地生境中的不同树冠层、树干生态位、一个种群在生态系统中,在时间空间上所占据的位置及其与相关种群之间的功能关系与作用。
基础生态位、一个物种能够占据的生态位空间,由物种的变异和适应能力决定,而非其地理因素。
基本生态位是实验室条件下的生态位,里面不存在捕食者和竞争。
实际生态位、自然界中真实存在的生态位。
物种流是指物种的种群在生态系统内或系统之间时空变化的状态。
2.微生物生态学的研究意义有哪些?①发现新的在工农业(如固氮)、食品(如发酵)、医药(如抗生素)和环境保护(如生物修复)方面有重要用途的微生物菌株(包括极端环境中微生物资源的发掘);②微生物在地球物质化学循环中具有重要作用;③开发和利用自然界中的微生物资源,保护好微生物基因资源;④控制有害微生物,利用微生物净化环境,保护环境,维持环境生态平衡;⑤保护人类健康和保护生态平衡发挥微生物的最佳作用。
3.微生物生态学主要研究内容有哪些?①正常自然环境中的微生物种类、分布及变化规律;②极端自然环境中的微生物;③微生物之间、微生物与动植物相互关系;④微生物在净化污染环境中的作用;⑤现代分子微生物生态学的研究方法。
4.生态系统的功能有哪些?物种流能量流食物链营养级信息流5.什么是微生物生态系统?其特点是什么?是指各种环境因子如物理、化学及生物因子对微生物区系(即自然群体)的作用和微生物区系对外界环境的反作用。
特点:微环境稳定性适应性7.简述物种流的含义及其特点。
是指物种的种群在生态系统内或系统之间时空变化的状态。
不同生态系统间的交流和联系。

崔战利老师:绪论●微生物有哪些共性?包括哪些类群?●微生物在哪些方面有所应用?(10分)●论述微生物及微生物学在生命科学中的地位。
●简述微生物在工业中的应用。
●试述微生物与农业生产的关系。
●微生物对人类生存环境有何影响?●微生物学生命科学基础理论的研究有何重大贡献?●你知道哪些有关微生物学发展史中较有影响的人物或者科学家,他们有什么重要贡献?●简要阐述微生物学发展过程(发展史)。
原核名词:菌落、芽孢、鞭毛伴孢晶体菌毛、LPS、基内菌丝、气生菌丝、孢子丝、糖被、异形胞、磁小体、原生质体、L型细菌、性菌毛贮藏物内含物古生菌抗酸染色原核生物异染粒PHB 周质空间菌丝羧酶体生物膜荚膜菌胶团菌株肽聚糖古菌F因子质粒菌苔简答题●G+、G-细菌的细胞壁化学成分、结构及相关的特点有何区别?●依据鞭毛的数目和着生位置不同,可将鞭毛菌分为哪几种类型?●试用渗透调节皮层膨胀学说解释芽孢耐热机制。
●细菌主要贮藏物的特点及生理功能是什么?●细菌的基本形态有几类? 其中球菌按分裂后排列不同分哪几种?●典型细菌大小和重量是多少?●蓝细菌及其特点?●简述革兰氏染色机理是什么?●比较链霉菌和大肠杆菌的异同。
●细菌的糖被化学组成是什么?对细菌本身有什么作用?与人类有哪些关系?细菌糖被依据其存在特点可分为几种类型?分别简述其特点。
●细菌芽孢的作用是什么?是什么样的结构和化学组成使之具有这种作用?简述芽孢的耐热机制及研究芽孢的意义。
根据芽孢的特点,你认为在生产实践和科学研究中应该如何利用和控制具有芽孢的细菌?芽孢为什么具有较强的抗逆性?●什么叫古生菌?请说明其细胞结构有哪些特点。
●简述细菌的细胞形态和细胞结构。
●是分析细菌的细胞形态与菌落形态间的相关性。
●细菌的荚膜和黏液层有什么区别?荚膜的成分和作用(糖被对细菌本身有什么作用?与人类有哪些关系?)是什么?●如果不利用显微镜,你将怎样鉴定一个细胞是原核的还是真核的?假设该生物体能方便地在实验室培养?●简述肽聚糖的组成和结构?举一例说明其在实践中的应用。

《生态学》复习资料(完整版)一、名词解释。
1、环境:某一特定生物体或生物群体生存空间一切要素的总和,包括生物生存空间内的各种条件。
生境:又称栖息地,是生物生活的空间和其中全部生态因素的综合体,即生物生活的具体场所。
因此,相对于一般“环境”而言,生境对生物具有更实际的意义。
2、种群:在特定时间内,占据一定空间的同种生物个体的集合。
3、互利共生:两物种相互有利的共居关系,并且彼此间有直接的营养物质交流,相互依赖、相互依存,双方获利。
4、群落演替:生物群落随时间的推移而发生的某些物种消失而某些物种侵入,使生物群落及其环境向着一定方向有顺序的发展变化的过程5、城市生态系统;城市生态系统是城市居民与其环境相互作用而形成的统一整体,也是人类对自然环境的适应、加工、改造而建设起来的特殊的人工生态系统。
6、生态系统:即生物群落与其生存环境之间,以及生物种群之间密切联系、相互作用,通过物质交换、能量转换和信息传递,成为占据一定空间、具有一定结构、执行一定功能的动态平衡体系。
7、生物群落:特定空间或生境中所有生物种群的集合。
包括植物、动物和微生物等各个物种种群,共同构成了生态系统中有生命的部分。
8、生物量:在某一特定的的调查时刻单位面积上积存的有机物质的量。
dB/dt=NP-H-D9、食物链:各种生物通过一系列吃与被吃的关系,把这种生物与那种生物紧密地联系起来,这种生物之间以食物营养关系彼此联系起来的序列,在生态学上被称为食物链。
食物网:在生态系统中生物间错综复杂的网状食物关系。
10、生态位:在自然生态系统中一个种群在时间、空间上的位置及其与相关种群之间的功能关系。
11、温室效应:透射阳光的密闭空间由于与外界缺乏热交换而形成的保温效应,就是太阳短波辐射可以透过大气射入地面,而地面增暖后放出的长波辐射却被大气中的二氧化碳等物质所吸收,从而产生大气变暖的效应。
12、生物多样性:指生命有机体及其赖以生存的生态综合体的多样化和变异性。

------------------------------------------------------------精品文档-------------------------------------------------------- 第十章微生物生态学单项选择题1.知识点:1(生态系统) 难易度:容易认知度:识记地球被科学家划分为4个圈,不包括下列哪一项( )。
选项A)土壤圈选项B)大气圈选项C)水圈选项D)岩石圈答案:A2.知识点:1(生态系统) 难易度:容易认知度:识记生态圈中,起着主导作用的是( )。
选项A)大气圈选项B)生物圈选项C)水圈选项D)岩石圈答案:B3.知识点:1(生态系统) 难易度:容易认知度:识记生物循环的特点是( )。
选项A)运转较缓慢选项B)可循环性选项C)运转迅速)以上均是D选项.答案:C11. 知识点:1(生态系统) 难易度:适中认知度:理解( ) 。
生态系统结构不包括下面哪一个方面选项A)外源能选项B)生物关系选项C)营养循环选项D)能量代谢答案:D12. 知识点:1(生态系统) 难易度:适中认知度:认知( ) 。
生物在生态系统物质循环中扮演着重要作用,但不包括选项A)生产者选项B)消费者选项C)分解者选项D)固定者答案:D13. 知识点:1(生态系统) 难易度:较难认知度:认知( ) 。
微生物生态系统自身的特点不包括选项A)微环境选项B)稳定性选项C)协调性选项D)适应性答案:C认知度:理解难易度:较难) 生态系统1(知识点:14.( ) 。
成熟的生态系统的平衡特点是选项A)生产者、消费者、分解者比例相同选项B)物质循环与能量循环协调畅通选项C)系统的输入和输出在比例上合理选项D)物质循环与能量循环大致相等答案:B15.知识点:2(微生物在自然界中的分布) 难易度:容易认知度:理解。
)土壤中三大类群体微生物以数量排序为(选项A)细菌>放线菌>真菌)细菌>真菌>放线菌B选项C选项)放线菌>细菌>真菌选项D)真菌>细菌>放线菌A答案:难易度:容易认知度:理解2(16.知识点:微生物在自然界中的分布) )。

微生物学复习资料微生物学复习资料1微生物复习整理材料一、名词解释1.微生物:是一切肉眼看不见或看不清的微小生物的总称。
它们都是一些个体微小、结构简单的低等生物,包括属于原核类的细菌(真细菌和古生菌)、放线菌、蓝细菌、支原体、立克次氏体和衣原体;属于真核类的真菌(酵母菌、霉菌、蕈菌)、原生动物、显微藻类;以及属于非细胞类的病毒、亚病毒(类病毒、拟病毒、朊病毒)。
2.微生物学:是一门在细胞、分子或群体水平上研究微生物的形态构造、生理代谢、遗传变异、生态分布和分类进化等生命活动基本规律,并将其应用于工业发酵、医药卫生、生物工程和环境保护等实践领域的科学,其根本任务是发掘、利用、改善和保护有益微生物,控制、消灭或改造有害微生物,为人类社会的进步服务。
3.细菌:是一类细胞细短、结构简单、胞壁坚韧、多以二分裂方式繁殖和水生性较强的原核生物。
4.细胞壁:是位于细胞最外的一层厚实、坚韧的外被,主要成分为肽聚糖,具有固定细胞外形和保护细胞不受损伤等多种生理功能。
5.原生质体:指在人为条件下,用溶菌酶除尽原有细胞壁或用青霉素抑制新生细胞壁的合成后,所得到的仅有一层细胞膜包裹的圆球状渗透敏感细胞。
7.细胞质:是指被细胞膜包围的除核区以外的一切半透明、胶体状、颗粒状物质的总称。
8.核区:又称核质体、原核、拟核或核基因组,指原核生物所特有的无核膜包裹、无固定形态的原始细胞核。
9.糖被:包被于某些细菌细胞壁外的一层厚度不定的透明胶体物质。
10.荚膜:是糖被的一种,包裹在细菌细胞壁外,有固定层次的胶黏物,一般成分为多糖、少数为多肽或多糖与肽的复合物。
11.鞭毛:生长在某些细菌表面的长丝状、波曲的蛋白质附属物。
具有运动功能。
12.芽孢:某些细菌在其生长发育后期,在细胞内形成一个圆形或椭圆形、厚壁、含水量低、抗逆性强的休眠构造,无繁殖功能。
13.孢囊:是一些固氮菌在外界缺乏营养的条件下,由整个营养细胞外壁加厚、细胞失水而形成的一种抗干旱但不抗热的圆形休眠体。

生态学重点生态学复习资料第一章绪论生态学:研究生物与其周围环境(包括非生物环境和生物环境)相互关系的科学。
生态系统:生态系统是在一定时间和空间内,生物与其生存环境以及生物与生物之间相互作用,彼此通过物质循环、能量流动和信息交换,形成的一个不可分割的自然整体。
一、论述你对生态学含义的理解。
1、生态学是研究生物与环境之间相互关系及其作用机理的科学。
这里的环境包括非生物环境和生物环境。
2、非生物环境是指光、温、水、营养物等理化因素;生物环境则是同种和异种的其他有机体。
3、生态学强调的是有机体与环境的相互作用,有机体与环境之间的而相互作用包括同种有机体之间的种内相互作用和异种有机体之间的种间相互作用。
4、现代生态学家公认为生态学是研究生物与环境之间相互关系及其作用和机理的科学。
二、简述生态学的发展历程及发展动力1 、生态学建立前期由公元前2世纪到公元16世纪的欧洲文艺复兴,是生态学思想的萌芽时期。
2 、生态学的建立和成长期从公元16世纪到20世纪50年代是生态学的建立和成长期。
曾被推举为第一个现代化学家的Boyle在1670年发表了低气压对动物的效应的试验,标志着动物生理生态学的开端。
3、现代生态学发展期从本世纪60年代至今,是生态学蓬勃发展的年代。
二次大战以后,人类的经济和科学技术获得史无前例的飞速发展,既给人类社会带来了进步和幸福,也带来了环境、人口、资源和全球性变化等关系到人类自身生存的重大问题。
这些是促进生态学大发展的时代背景和实践基础;而近代的数学、物理、化学和工程技术向生态学的渗透,尤其是电子计算机、高精度的分析测定技术、高分辨率的遥感仪器和地理信息系统等高精技术为生态学发展准备了条件。
三、什么是全球变化?论述当前人类所面临的主要生态问题。
1、全球变化学是研究地球系统整体行为的一门科学。
它把地球的各个层圈(如大气圈、水圈、岩石圈和生物圈)作为一个整体,研究地球系统过去、现在和未来的变化规律和控制这些变化的原因和机制,从而建立全球变化预测的科学基础,并为地球系统的管理提供科学依据。

微生物生态学重点知识点归纳总结
本文档旨在对微生物生态学的重点知识点进行归纳总结。
以下是其中的一些重要内容:
1. 微生物生态学概述
- 微生物生态学的定义
- 微生物在环境中的分布和生态功能
- 微生物与其他生物之间的相互作用
2. 微生物群落结构与功能
- 微生物群落的组成和多样性
- 微生物对环境的影响和生态功能
- 微生物群落的稳定性和演替过程
3. 环境因素对微生物群落的影响
- 温度、湿度、光照等环境因素对微生物群落的影响
- pH、氧气浓度等环境因素对微生物群落的影响
- 其他环境因素对微生物生态的影响
4. 微生物在环境修复中的应用
- 微生物在土壤修复中的应用
- 微生物在水体净化中的应用
- 微生物技术在环境修复中的前景和挑战
5. 微生物与人类健康的关系
- 微生物与人体的共生关系
- 微生物与人类疾病的关联
- 微生物在医疗和健康保健中的应用
以上仅为微生物生态学的一部分重点知识点,希望对您有所帮助。
如需更详细的了解,请参考相关文献和学术资料。


微生物生态学复习材料一、名词解释1.生境:发现有某一生物的物理区域。
2.生态位:生物生长的空间范围、生物在这一生境内的活动、功能作用及与其他生物的相互作用。
3.土著微生物:在一个给定的生境中那些能生存、生长和进行活跃代谢的微生物,并且这些微生物能与来自其他群落的微生物进行有效的竞争。
4.外来微生物:来自于其他生态系统的微生物,这些微生物不能在这一生境中长期生活下去。
5.微生物区系:一个给定区域中微生物的种类、数量及其参与的物质循环。
6.生理群:按生理特性将微生物划分为不同的类群。
7.优势种:在一定条件下或在一个生理群中常只有少数种类占优势,即在最高稀释度平皿中出现较多菌落数的菌种,该菌种称优势种。
8.水体富营养化:当水体中N、P营养元素的含量大量增加至远超正常指标,导致原有生态系统破坏,藻类或某些细菌数量猛增,其他生物种类减少,水质变坏的现象。
9.极端微生物:最适合生活在极端环境中的微生物。
10.嗜冷微生物:最低生长温度0℃以下,最适生长温度≦15℃,最高生长温度20℃左右的微生物。
11.群体密度:单位体积内的微生物个体数目。
12.共代谢:在某种特殊底物A上生长的一个微生物群体A能顺便氧化底物B,而底物B不能作为群体A的碳源和能源,但是底物B被群体A氧化过的产物却能被另一种微生物群体B利用。
13.拮抗:在一个环境中,一个群体产生的代谢产物使共处的另一群体生长受抑制,而本身不受影响的种间关系。
14.竞争作用:两个或多个群体共同依赖同一个生长基质或环境条件,结果使一方或双方群体大小或生长率受限制的现象。
15.根际效应:在根系分泌物选择下促进一类群微生物生长发育的现象。
16.连作障碍:长期种植同一作物造成根际有毒物质积累,虽然每年施肥充足和采用相同的栽培措施,但作物产量仍每年下降的现象。
17.菌根:某些真菌和植物根系的互惠共生联合体。
18.丛枝菌根真菌:形成菌根时菌丝直接入侵根表皮细胞内和细胞外,不形成哈氏网的真菌。
微生物生态学基础微生物生态学是生态学的一个重要分支,研究微生物在自然环境中的分布、相互作用以及对生态系统功能的影响。
微生物是地球上最古老、最丰富的生物群体之一,它们在碳循环、氮循环等关键生态过程中扮演着重要角色。
本文将介绍微生物生态学的基础知识,包括微生物的分类、功能和生态位,微生物群落的组成和结构,以及微生物在自然生态系统中的作用。
一、微生物的分类、功能和生态位微生物是一类可以只能用显微镜观察到的生物,包括细菌、真菌、古菌和原生生物等。
它们广泛存在于地球的各个环境中,包括土壤、水体、大气和生物体内等。
微生物具有多样的功能,包括分解有机物、固氮、光合作用和产生生物活性物质等。
在生态系统中,微生物根据其对环境要求的不同,分别占据不同的生态位,与其他生物相互作用。
二、微生物群落的组成和结构微生物群落是由多种微生物组成的复杂生态系统。
微生物群落的组成受到环境因素和相互作用的影响。
环境因素包括温度、湿度、光照、pH值等,这些因素直接影响着微生物的生长和繁殖。
相互作用包括竞争、共生和协同等,这些相互作用关系会改变微生物群落的结构。
微生物群落的结构可以通过分子生物学技术,如16S rRNA和ITS扩增子测序等方法进行分析。
三、微生物在自然生态系统中的作用微生物在自然生态系统中扮演着重要角色。
首先,微生物在有机物的分解过程中发挥着关键作用。
它们通过分解有机物,将有机质转化为无机形态的氮、磷等元素,使之再次进入循环。
其次,微生物在固氮过程中具有重要功能。
一些细菌和古菌具有固氮酶,能够将大气中的氮气转化为植物可以直接利用的氨。
此外,微生物还参与了氮循环的其他关键过程,如硝化、反硝化和氮捕获等。
最后,微生物还能够产生多种生物活性物质,如抗生素、植物生长促进物质和有机酸等,对生态系统的功能具有重要影响。
综上所述,微生物生态学是生态学领域中一个重要的研究方向。
通过对微生物的分类、功能和生态位的研究,可以更好地理解微生物在生态系统中的角色和功能。
微生物生态学(microbial ecology)是在微生物和生态学发展过程中形成的交叉学科,为生态学的一个分支学科,是研究微生物与其生存环境、微生物群体之间相互关系、相互作用的科学,
生境(habitat)是指微生物能够在其中生存并执行其特定功能的微小环境,又称之为微环境(microenvironment)或微小生境(microhabitat)
龛(niche)包含为生境更为广泛的含义,它不但包含了生物生存的空间概念,还蕴涵着功能作用以及不同温度、湿度等环境变化中的位置,也称为生态学。
种群(population)具有相似特性和生活在一定空间内的同种个体群称之为种群。
群落(community)一定区域内或一定生境中各种微生物种群相互松散结合的一种结构和功能的单位称之为群落。
生产者和消耗者生产者和消耗者是构成自然界生态系统物质能量循环的重要元素。
生物钟绿色植物的光合作用摄取太阳能,转化为化学能,将无机物转化为有机物,是重要的生产者。
动物消耗有机物,使能量与物质重新分配,是消耗者。
Microbial Ecology绪论1.名词解释:微生物生态学:是研究微生物与其周围生物和非生物环境之间相互关系的一门科学。
微生态学:是生态学的一个层次,是研究正常微生物在细胞或分子水平上相关关系的科学环境、自然环境+生物环境生境、指生物的个体、种群或群落生活地域的具体环境。
生物+非生物栖息地、生物生活或居住的范围的物理环境。
如林地生境中的不同树冠层、树干生态位、一个种群在生态系统中,在时间空间上所占据的位置及其与相关种群之间的功能关系与作用。
基础生态位、一个物种能够占据的生态位空间,由物种的变异和适应能力决定,而非其地理因素。
基本生态位是实验室条件下的生态位,里面不存在捕食者和竞争。
实际生态位、自然界中真实存在的生态位。
物种流是指物种的种群在生态系统内或系统之间时空变化的状态。
2.微生物生态学的研究意义有哪些?①发现新的在工农业(如固氮、食品(如发酵、医药(如抗生素)和环境保护(如生物修复)方面有重要用途的微生物菌株(包括极端环境中微生物资源的发掘);②微生物在地球物质化学循环中具有重要作用;③开发和利用自然界中的微生物资源,保护好微生物基因资源;④控制有害微生物,利用微生物净化环境,保护环境,维持环境生态平衡;⑤保护人类健康和保护生态平衡发挥微生物的最佳作用。
3.微生物生态学主要研究内容有哪些?①正常自然环境中的微生物种类、分布及变化规律;②极端自然环境中的微生物;③微生物之间、微生物与动植物相互关系;④微生物在净化污染环境中的作用;⑤现代分子微生物生态学的研究方法。
4.生态系统的功能有哪些?物种流能量流食物链营养级信息流5.什么是微生物生态系统?其特点是什么?是指各种环境因子如物理、化学及生物因子对微生物区系(即自然群体)的作用和微生物区系对外界环境的反作用。
特点:微环境稳定性适应性7.简述物种流的含义及其特点。
是指物种的种群在生态系统内或系统之间时空变化的状态。
不同生态系统间的交流和联系。
微⽣物⽣态学第⼀章1⽣态学(Ecology):研究⽣物与其周围环境,包括⾮⽣物环境和⽣物环境相互关系的科学2.⽣态学的分⽀学科基础(纯粹)⽣态学按组织层次分:个体⽣态学,种群⽣态学,群落⽣态学,⽣态系统⽣态学等按⽣物类别分动物⽣态学,植物⽣态学,微⽣物⽣态学,真菌⽣态学等按栖息环境分陆地⽣态学,海洋⽣态学,河⼝⽣态学,淡⽔⽣态学等3.应⽤⽣态学:应⽤⽣态学、污染⽣态学、⼈类⽣态学、城市⽣态学、农业⽣态学、资源⽣态学。
4.⽣态因⼦环境中对⽣物的⽣长、发育、⽣殖、⾏为、分布有着直接或间接影响的环境要素5.⽣物因⼦:⽣物种内和种间的相互关系;⾮⽣物因⼦:光、温度、湿度、降⽔、⼟壤、⼤⽓等。
6.⽣态因⼦的作⽤特点:综和性、⾮等价性、不可替代性和互补性、限定性。
7.⽣物与环境的关系的基本原理:⽣物势和环境阻⼒⽣物势:⽣物在没有任何限制的环境中增长的潜在速率环境阻⼒:环境对⽣物增长速率的限制因素8.⽣物与环境的关系的基本原理内稳态机制:⽣物控制⾃⾝的体内环境使其保持相对稳定的机制意义:提⾼⽣物对⽣态因⼦的耐受范围9.种群(population) :由⼀定时间内占有⼀定地区的⼀群同种个体组成的⽣物系统10.种群密度⼀定时间内,单位⾯积上或单位空间内的个体个数11.种群分布型:随机分布、均匀分布、群聚分布12.种群分布的类型图:集团分布、均匀分布、随机分布。
13.种群的年龄结构:增长性、稳定型、衰退型14.种群存活曲线(survivorship):在各年龄阶段种群的存活率曲线15.基本类型:Ι型(凸型存活曲线)哺乳动物、⼈、Π型(直线型存活曲线)鸟类、Ⅲ型(凹型存活曲线)低等动物16、种群增长率(出⽣率+迁⼊率)-(死亡率+迁出率)17、种群增长的形式:逻辑斯缔增长“S”形、指数式增长“J”形18、类型 A B 特点竞争- - 彼此互相抑制捕⾷- - A种杀死或吃掉B种中性O O 彼此互不影响共⽣+ + 彼此有利,分开后不能⽣活合作+ + 彼此有利,分开能独⽴⽣活附⽣+ O A种有益,B种⽆影响偏害- O 对A有害,对B⽆利也⽆害寄⽣+ - 对A有利,对B有害群落(community):在⼀定时间内居住于⼀定环境中的各种群组成的⽣物系统19、⽣物群落的分类按植物⽣活型分为:、森林、草原、荒漠按地理⽓候分为:、热带群落、亚热带群落、温带群落20、主要群落类型:森林:、热带⾬林、温带落叶阔叶林、针叶林21、主要群落类型:热带草原、温带草原、冻原、荒漠22、群落的基本特征种类特征:种组成是区别不同群落的⾸要特征物种间的相互影响:构成群落的种群之间必须相互协调、平衡结构特征:⽣物群落具有⼀系列的结构特点,包括形态结构、⽣态结构和营养结构动态特征:⽣物群落的运动形式包括季节动态、年际动态、演替与演化23、群落演替图:裸底阶段、沉⽔植物阶段、浮叶根⽣植物阶段、挺⽔植物和沼泽植物阶段24、⽣态系统(ecosystem):在⼀定空间内由⽣物和⾮⽣物成分组成的⼀个功能整体及⽣物圈能流和物质循环的⼀个功能单位25、⽣态系统的基本组分⾮⽣物成分太阳辐射能,⽆机物质(⼤⽓、⽔),有机物质⽣物成分⽣产者,消费者,还原者26、⽣态系统的基本特征:核⼼是⽣物群落、地区特点和空间结构、时间特征、三⼤功能类群参与代谢活动、动态平衡特征、开放性。
生态学复习生态因子:指环境中对生物生长、发育、生殖、行为和分布有直接或间接影响的环境要素。
生态环境:所有生态因子构成生物的生态环境。
生境:具体的生物个体和群体生活地段上的生态环境。
生态因子作用特征:综合作用;主导因子作用;阶段性作用;不可替代性和补偿性作用;直接作用和间接作用。
霍普金斯物候定律:在其他因素相同的情况下,北美洲温带地区每向北移动纬度1度,向东移动经度5度,或上升400英尺,植物的阶段发育在春天和初夏将各延迟4天;而秋天则相反,即向北移动纬度1度,向东移动经度5度,或向上推进400英尺,都要提早4天。
种群:在同一时期内占有一定空间的同种生物个体的集合。
逻辑斯蒂方程:dN/dt=rN(1-N/K) 曲线分为五个时期:开始期;加速期;转折期;减速期;饱和期。
生态入侵:由于人类有意识或无意识地把某种生物带入适宜其栖息和繁衍的地区,其种群不断扩大,分布区逐步稳定地扩展,这个过程称为生态入侵。
密度效应:在一定时间内,当种群的个体数目增加时,邻接个体间出现的相互影响,称为密度效应。
他感作用:也称异株克生,通常是指一种植物通过向体外分泌代谢过程中的化学物质,对其他植物产生直接或间接的影响。
他感的生态学意义:1)对农林业生产和管理具有重要意义,如农业的歇地。
2)对植物种群的种类组成有重要影响,是造成种类成分对群落的选择性,以及某种植物的出现引起另一类消退的主要原因之一。
3)引起植物群落演替的重要内在原因之一。
动物竞争的方式:竞争食物;竞争配偶;雌性个体竞争产卵和育幼场所。
利他行为:指一个个体牺牲自我而使社群整体或其他个体获得利益的行为。
竞争排斥原理:生态位相同的两个种不能在同一地区长期共存。
种内竞争的类型:负竞争;分摊竞争;争夺竞争。
种间竞争类型:利用竞争型;干扰竞争型。
竞争的特征:竞争结果的不对称性;对一种资源的竞争,能影响对另一种资源的竞争结果。
生态位:指物种在生物群落或生态系统中的地位和角色。
微生物生态学复习资料指来自于其他生态系统的微生物,所以这些微生物不能在这一生境中长期生活下去。
群落(Community):指一定区域里,各种群体(Population)相互松散结合的一种结构单位。
生态系统:生态系统就是在一定的时间和空间内,生物和非生物的成分之间,通过不断的物质循环和能量流动而相互作用、相互依存的统一体,构成一个生态学的功能复合体。
生态系统=生物群落+无机环境。
影响土壤中微生物分布的因素●土壤颗粒性质腐殖质》砂土●土壤水分游动微生物●氧气上层好氧微生物多(穴居动物活动可以给微生物好氧生长提供条件)●pH pH对营养物质的利用,微生物吸附,胞外酶的产生和分泌产生影响●温度蓝细菌能抗变化范围很大的温度;耐寒的藻类(雪藻)●营养状况有机物对自养细菌有抑制作用(刍溪藻喜欢在营养丰富的鸟粪中)(土壤颗粒中细菌的不均匀分布)●人类生产活动三.淡水微生物的共同特征:1 能在低营养物浓度下生长2 微生物是可以游动的3 表面积和体积比大(柄细菌),有效吸收营养。
研究极端环境中微生物的意义●研究其强而稳定的特殊结构、机能和遗传基因以及应答因子,对阐明物种起源、生物进化具有重要意义。
●研究其生理生化特性,可用于量度地球上生命生存的理化极限,对探索宇宙星球上的生物有参考价值;●可探索出新的生理途径,生产新酶和新的生物制剂,使用于特殊环境条件,如煤脱硫、冶炼金属、处理有毒废水、高压深油井探矿、纤维素高温发酵酒精等。
●研究成果可以大大促进微生物在环境保护、人类健康和生物技术等领域的应用。
嗜冷微生物(psychrophiles)☐0℃以下或3~20℃能生长的微生物,☐最适生长温度不超过15℃,☐最高生长温度不超过20℃。
耐冷菌(psychrotrophs)☐0~5℃可生长繁殖,☐最适生长温度可达20℃以上的微生物嗜中温微生物(mesophilies)☐13~45℃下能生长的微生物低温微生物适应低温的分子机理:1.通过信号传导使低温微生物适应低温环境膜蛋白的磷酸化、去磷酸化反应来感应温度变化耐冷菌Pseudomonas syringae脂多糖和膜蛋白的磷酸化和去磷酸化反应和温度变化有关2.调整细胞膜脂类的组成维持膜的流动性、通透性,保证膜的正常生理功能(膜的改变)增加不饱和脂肪酸比例,使细胞膜脂类处于流动状态,保持物质转运能力和酶活力增加不饱和脂肪酸的比例,增加不饱和脂肪酸的合成缩短脂肪酸链的长度,增加脂肪酸支链的比例,减少环状脂肪酸的比例等(有利于膜脂熔点的降低并在低温下保持液晶态)脂含量升高、膜面积增大(有利于提高菌体细胞对营养物质的吸收能力)3.低温微生物的蛋白质和蛋白质合成(蛋白质的改变:酶分子的改变、其它蛋白质的改变)嗜冷菌合成大量的低温酶类,弥补因低温导致的反应速率下降的问题;嗜冷菌合成产生不同类型的低温酶类(同功酶),在一定范围的不同温度下始终保持代谢活力,维持生命现象。
低温酶在低温下具有高催化率和高柔顺分子构象。
嗜冷菌中蛋白质以单体和多聚体的形式存在(Vibrio中异柠檬酸脱氢酶的单体比二聚体对热敏感)4.低温微生物通过产生冷冲击蛋白(cold shock protein)适应低温环境当生长温度从21℃降到5℃时,嗜冷酵母能在12 h内合成26种冷冲击蛋白。
5.tRNA的改变嗜冷菌的tRNA转录后被修饰的程度较低,而这些修饰仅是维持tRNA的基本结构。
维持较好的柔性以及动力学上的流动性。
四. 嗜热菌:在55℃或55℃以上生长的微生物都叫做嗜热菌。
①专性嗜热菌:最适生长温度在65℃~70℃之间,当生长温度低于35℃时,生长便停止。
②兼性嗜热菌(耐热菌):生长温度范围介于嗜热菌和嗜中温菌生长温度(13℃~45℃)之间,其最适生长温度在55℃~65℃之间。
③抗热菌:最适生长温度在20℃~50℃之间,但也能在室温下生长。
古细菌:又称古菌、原细菌。
是一种原核生物。
为单细胞生物,无真正的核,染色体含有组蛋白,RNA聚合酶组成比细菌的复杂,翻译时以甲硫氨酸为蛋白质合成的起始氨基酸,细胞壁中无肽聚糖。
分布:深海的火山口、陆地的热泉以及盐碱湖代表性古细菌:嗜酸嗜热细菌嗜盐细菌嗜甲烷菌。
高温下微生物生命的分子机理:1.细胞膜⏹增加脂肪酸烷基链的长度⏹降低烷基链的不饱和程度⏹增加甲基分枝链的比例。
1)嗜热脂肪芽孢杆菌、栖热菌属细胞中含有高比例的长链饱和脂肪酸和具有分枝的脂肪酸,异和前异脂肪酰基链是主要的。
2)嗜热芽孢杆菌细胞膜中含有w-环己基脂环族的脂肪酸,有利于在低pH和高温下维持膜的半渗透功能。
3)含类异戊醇,形成共价交联的双层膜,在广泛温度范围内保持膜的液晶状态。
2.呼吸链蛋白呼吸链的组分和ATP酶的抗热性影响微生物的最高生长温度,嗜热脂肪芽孢杆菌中的ATP酶热稳定性高,对解离剂的抗性大。
3.tRNA从嗜热微生物中提取的tRNA热稳定性高(碱基取代,硫化)。
4.多聚胺多聚胺在调节核酸合成、蛋白质合成和细胞分裂方面起着重要作用。
✧嗜中温菌中仅含有二聚胺和三聚胺,嗜热菌中含有更长链的多聚胺✧嗜热脂肪芽孢杆菌含有精胺和亚精胺✧多聚胺可以恢复无细胞抽提物的蛋白质合成能力✧热亚精胺具有热抗性活力,高温下稳定核糖体和mRNA与氨基酸tRNA之间的一种三元复合物。
5.蛋白质✧氨基酸的取代✧生长温度在某种程度上也会决定蛋白质的热稳定性✧增加分子内离子键结合力而稳定蛋白质✧合成热抗性蛋白✧底物和效应物可稳定某些酶✧通过化学试剂对酶进行化学修饰或把酶通过共价键交联在不溶性的多聚物上,改变蛋白质的分子表面,提高酶的热稳定性✧金属离子可稳定高温下的蛋白质分子✧真菌和酵母中多羟基醇提高蛋白质的热稳定性✧低水活度利用有机溶剂和水混合物制备的酶热稳定提高。
五.嗜酸菌是一种能在低pH条件下生长和繁殖的极端环境微生物,通常在pH2~5生长很好,pH5.5以上生长不好。
抗酸微生物能在强酸环境中生长或生存,但是最适生长pH在4~9之间的微生物;专性嗜酸微生物必须在pH≤3的环境中才能生长的微生物。
嗜酸菌的应用:•细菌冶金氧化Fe2+和S0的细菌能产生酸性的含有Fe3+的溶液,Fe3+可氧化矿石的大量成分,能使Cu2+,U4+,Sn2+,Zn2+,Ni2+,呈可溶状态。
利用氧化亚铁硫杆菌通过微生物沥取法可以从低含量的矿物中大量提取Cu,能耗小。
是开采贫矿和尾矿的有效办法,用细菌浸出Cu的速度比完全氧化快56-60倍。
•煤和石油脱硫利用嗜酸热硫化叶菌氧化无机硫和有机硫化物,减少二氧化硫污染。
•生产肥料利用硫杆菌氧化元素硫或硫化物产生硫酸,来分解磷矿粉,提高高氟硫酸钙的溶解度,提高肥效。
•嗜酸菌还被广泛应用到重金属污染土壤的生物修复、耐热酶的提取。
•嗜酸微生物在环境保护中的作用酸性的矿山废水是由于嗜酸菌氧化分解硫化矿石行成的,危害十分严重。
氧化亚铁硫杆菌氧化Fe2+ 形成Fe3+ ,析出沉淀。
六.嗜碱微生物(Alkalophilic microorganisms)是指碱性环境中最适生长的微生物,可区分为耐碱菌和专性嗜碱菌。
耐碱微生物:在pH8.5~9.0之间最适生长,中性条件下亦能生长的微生物。
专性嗜碱微生物:一般情况下在pH≤7时不能生长,最适生长的pH值9左右,pH10以上还能生长的微生物。
嗜盐嗜碱微生物:除了需要高的pH外,还需高浓度的盐。
嗜碱微生物产生的酶:蛋白酶:洗涤剂的添加剂,不受表面活性剂和助剂的影响,在碱性条件下提高去污能力;嗜碱杆菌产的蛋白酶稳定、产量高,酶是可溶的,可长时间保存;碱性蛋白酶用于动物皮革的去毛作用,克服石灰硫酸钠处理法环境污染的缺点;碱性的弹性蛋白酶在pH11下降解动物组织的弹性蛋白、角蛋白和胶原蛋白;环状糊精葡萄糖转移酶:使淀粉转化为环状糊精(CDs);淀粉酶:水解淀粉,最适pH为10.5;纤维素酶:处理化工和纺织工业排出的碱性废水;木聚糖酶:转化木聚糖为木聚二糖和寡聚糖,处理人造纤维废物;果胶酶:果胶裂解酶用纸张生产工艺改良;碱性脂肪酶和青霉素酶七.在高浓度NaCl环境中发现的嗜盐微生物主要有微藻和嗜盐细菌。
抗盐微生物➢最适生长的盐浓度在0~0.3 mol/L NaCl 之间,➢能生长的盐浓度在0~1 mol/L NaCl之间(5.8%)。
主要有肠道细菌和各种微藻,G-细菌盐单胞菌(Halomonas)也属于抗盐微生物。
H.elongata是抗盐能力最大的微生物(5.5mol/L NaCl)。
中度嗜盐微生物(至少0.5%但不超过26%) ➢最适生长的盐浓度在0.2~2.0 mol/L NaCl之间,➢能生长的盐浓度在0.1~4.5 mol/L NaCl 之间(26.1%)。
主要有某些真细菌、蓝细菌和微藻,如死海和盐湖中存在的中度嗜盐的专性厌氧发酵细菌盐拟杆菌(Halobacterioids)、生孢盐细菌(Sporohalobacter)、盐厌氧细菌(Haloanaerobium),它们能降解各种有机物。
极端嗜盐微生物➢最适生长的盐浓度在 3.0~5.0 mol/L NaCl之间(29%),➢能生长的盐浓度在1.5~5 mol/L NaCl之间。
主要有盐杆菌和盐球菌,它们属于古细菌。
八.微生物群体内的相互作用:1.微生物群体内不同个体也存在正和负的相互作用(关键决定于群体密度);2.微生物群体内的正作用——合作(协同作用)接种量大小对延滞期的影响(代谢产物、生长因子-群体感应)如果群体密度小,个体的代谢产物不能得到合理使用,生长缓慢,生长率增加也缓慢;如果群体密度大,生长速率加快。
对底物降解、遗传物质交换、病原菌致病和对不良环境抵抗都存在协同作用(遗传物质的接合交换需要高群体密度 >105个细胞/ml;在群体密度低的时候通过形成凝结块促进遗传物质交换:粪肠球菌受体细胞产生外激素(Pheromones),外激素诱导供体菌合成凝结素,使供受体形成凝结块有利于遗传物质的交换.)通过信号传递达到协同作用,也是保护种的延续的有效途径。
粘液菌的纲柄菌属可以聚集到一个中心细胞上形成子实体而寻找食物,遇到有毒物质也可通过聚集作用避开伤害。
3.微生物群体内的负作用——竞争(1)对食物的竞争;(营养物、光、空间和宿主)病毒和蛭弧菌竞争受体上的空间(2)产生有毒物质进行竞争;土壤亚表面有机酸的累积会使葡萄糖代谢受到抑制。
竞争的结果导致生长率下降。
不同微生物群体间的相互作用:1、作用效应①一方得益,另一方无影响;②双方都得益;③一方得益,另一方受害。
2、相互作用的种类(8种)0:无影响+:正效应-:负效应共代谢指在某种特殊底物上生长的一种群体能顺便氧化第二种底物,而第二种底物不能作为这一种微生物群体的碳源和能源。
Eg: Jackson Foster观察到依靠石蜡烃生长的诺卡氏菌,在加有芳香烃的培养液中,对芳香烃具有氧化作用。